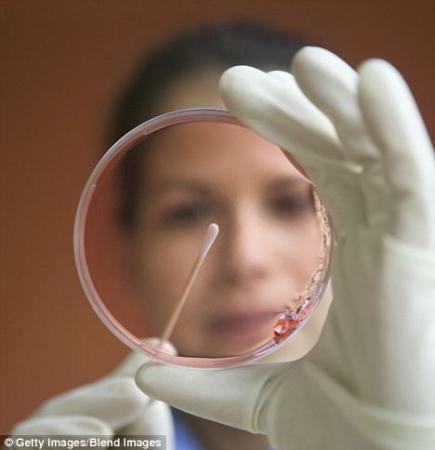
人造肉

科学家声称,他们已经破解了实验室人造肉之谜,他们现在的工作是找出一种可行的方法,将它推向市场,并获得利润。
目前,世界上大约有30个团队在研究人造肉——大量的资金和人才倾注在这项技术上。如果成功了,这项技术将可以解决世界饥饿问题。这种不经过屠宰得来的肉完全在实验室生成,来自于动物肌肉细胞。它比真肉更环保,也会减少动物的痛苦。
动物福利组织Peta已经承诺,不论是哪一个科学家,只要能够在2016年前发明出在味道纹理上和真肉相差无几,并且在美洲10个国家至少销售2000英镑的人造鸡肉,将会得到100万美元的奖励。
现在,《食品安全新闻》发表的一系列报道表明,2012年将是人造肉具有突破性进展的一年。

如果人造肉能够产业化生产,那么就不需要大量屠宰了。
来自荷兰马斯特里赫特大学的Mark Post博士承诺说,不需多长时间,人造肉就会在他的实验室里研制成功。他的研究由荷兰政府和一笔30万欧元的匿名款项资助。但是他不能获得Peta的奖赏,因为他研究的是牛肉而不是鸡肉。
与此同时,美国资助密苏里大学聘请Nicholas Genovese和R. Michael Roberts一起研究人造肉。他们都是干细胞和家禽研究领域的顶级专家。
如果科学家发现试管肉工业化生产的方法,那么就有望削减其价格,使之比真正的肉便宜。这还有待观察。但是,不管科学家有没有找到这个方法,最关键的是这种肉吃起来要像人们吃真正的猪肉、羊肉、香肠一样,而不是感觉它就是在试管中生成的。

在人造肉的生成过程中,肌肉纹理是最难创建的。所以首批试管肉可能最先用于加工肉类产品,例如汉堡和香肠。为了制造这些肉,科学家从动物身上提取肌肉细胞,把它们培养在一种蛋白质液体培养基里,使其大量繁殖,产生一种粘性组织,最后慢慢形成肉。一些研究人员说,如果方法得当,培养原料和环境都适宜,10个猪肌肉细胞可以在两个月内产生50000吨肉。
Peta说他们之所以决定支持试管肉研究,是因为很多人都有“肉瘾”,必须得吃肉不可。







